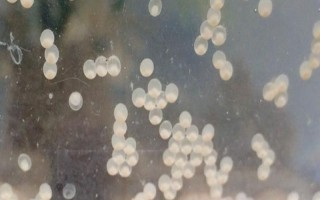
鱼卵能存活多久，鱼的种类不同鱼卵的存活情况也不同

低价蜂蜜是不是假的,保存得当可永不变质
蜂巢蜜并无固定的保质期。蜂巢蜜是蜜蜂酿制成熟并封盖的蜜脾,而蜂蜜富含天然抗菌物质(比如溶菌酶等),再加上蜂蜡也能对蜂蜜起到保护作用,因此它没有严格意义上的保质期。如果将蜂巢蜜作为食品销售,保质期通常为...
08-25
鱼卵的存活时间因品种而异,大多数品种的鱼卵离水后会快速失活、死亡,少数品种的鱼卵能在干燥处存活数月,甚至能存活1-2年。
鱼卵经过受精才具备孵化能力,否则会逐渐腐烂,破坏水质,因此要及时捞出未受精卵。
1、鱼的种类有很多,鱼卵的存活情况也不一样,大部分鱼卵离水后就会失去活性,立刻就会死掉。

2、但也有一些鱼卵可以在干燥的环境中存活几个月的时间,甚至有的可以活一两年之久。

3、需要注意的是,鱼卵需要受精后才能孵化出小鱼,否则只会慢慢腐烂,影响水质情况,所以未受精的卵要尽快捞出。

1、隔离
发现鱼缸里有鱼卵后,需要及时将鱼卵和亲鱼隔离开。很多鱼有吞卵的习性,所以如果不把鱼儿捞出来的话,它会将鱼卵吃掉。当然,也可以提前准备尼龙网板,这样鱼卵会落到网板下层,鱼儿就吃不到了。

2、检查
鱼卵分受精和未受精两种,受精卵可以孵出小鱼,未受精的卵会污染水质,所以需要做好检查工作,发现鱼卵已经是白色透明的,中间没有出现黑点,说明没有受精成功,需要将其捞出清理掉,不然会影响受精卵的孵化。

3、孵化
受精卵在孵化期间,一定要注意保持水温,通常情况下,温度越高,孵化的速度越快,但也不能太高,保持在20℃左右就可以了。另外,还要用氧气泵充氧,保持水体有足够的氧气。

1、鱼卵通常是球状或椭圆形的,根据鱼儿的种类不同,颜色也不一样,但一般几天后都会变色。

2、鱼卵孵化对水流和氧气都有一定的要求,如果水体静止,氧气也比较少的话,孵化起来就非常慢。

3、另外在鱼儿产卵后,需要检查一下是否受精,未受精的卵需要及时清除,不然腐烂后就会污染水质,对鱼儿的健康不利。
标签: 鱼卵能存活多久
相关文章
蜂巢蜜并无固定的保质期。蜂巢蜜是蜜蜂酿制成熟并封盖的蜜脾,而蜂蜜富含天然抗菌物质(比如溶菌酶等),再加上蜂蜡也能对蜂蜜起到保护作用,因此它没有严格意义上的保质期。如果将蜂巢蜜作为食品销售,保质期通常为...
08-25
支撑身体:袋鼠在静立不动时,其尾巴可用于支撑身体,让后腿得到休息。控制方向:鸟类的尾巴可用于保持身体平衡,同时可以调整飞行方向。水中游动:鱼儿的尾巴可用于转向,同时可帮助鱼快速游动。寻找配偶:公鸡的尾...
04-06
下雨时,蝴蝶一般就近躲藏,比如花间、树叶背面、草丛、麦田中。下雨时,蝴蝶的翅膀并不会被雨水打湿,因为蝴蝶翅膀由数百片细小鳞片组成,可阻挡雨水。但如果雨势较大,蝴蝶将会被雨滴砸至地面,严重时可能无法再飞...
01-19
麻雀有窝,它们会在窝中休息、育雏。麻雀常在屋檐下等人类较多的地方做窝,一些麻雀则会在野外的树上做窝,比如特别是树洞内。当一棵树上具有很多树洞时,容易吸引大量麻雀来“安家落户”,因为麻雀喜欢集群生活。一...
08-23
饵料配方:用白面+玉米面+糠炒熟,加入菜末、大蒜汁、醋、白酒,搅拌均匀后放置在密封的瓶子中放置半天。诱捕管理:将饵料包好后放入虾笼中,虾笼于傍晚时下笼,为防止虾进笼后会顺水出去需要将口子放大。一、河虾...
04-01
生黄豆可以打豆浆喝,但打浆后要煮熟,否则容易引发不良症状,比如呕吐、腹泻、头晕等。黄豆里面含有胰蛋白酶,如果不进行灭活处理,容易影响人体吸收和消化蛋白质。用生黄豆磨豆浆,要提前浸泡6-8小时使其软化,...
01-30
凉拌黄玻璃树芽:首先将黄玻璃树芽用开水略微烫一下,然后将葱切成末并与酱油、白糖、精盐、味精等调味料拌匀,接着浇入热香油调成汁,最后将调味汁和黄玻璃树芽拌匀即可食用。黄玻璃树芽茶:将黄玻璃树芽洗净晒干,...
03-22
夏季上市的水果有枇杷、桃子、荔枝、西瓜、山竹、木瓜、杨梅等。枇杷:5-6月份所产枇杷尤为香甜,故而有着“五月枇杷似黄橘”的说法。桃子:桃子上市时间为5-9月份,最佳上市时间为7月份。荔枝:荔枝于每年夏...
02-17
粽子用高压锅煮需要15-20分钟,用普通锅煮要煮半小时至三个小时左右。粽子通常都是由糯米包成的,所以比较难煮熟,煮得时间越久就会越软烂,食用后也会更容易消化,比较适合给老人和孩子吃。常见的粽子种类有北...
09-05
轮点型毒素病:种植抗病品种,对木瓜套袋,与玉米间作,利用网室栽培。炭疽病:收集病残体并集中烧毁,开花后、果实采收前7天,喷施80%大生M-45可湿性粉剂1000倍液,每隔7-10天喷1次。疫病:合理轮...
04-16
热点文章
林蛙如何区分公母,是同一个品种
宇翔9号玉米栽培技术要点,普通玉米品种
九圣禾M138棉花栽培技术要点,播种时亩施底肥50千克复合肥
中棉EB001棉花栽培技术要点,夏播生育期94天
天隆优717水稻栽培技术要点,粳型杂交水稻品种
犬猫自身免疫性溶血性贫血治疗方案,常表现为精神沉郁且不愿活动
氟磺胺草醚可以打哪些作物,在土壤中的残留期较长
红头鱼为什么便宜,是鲉形目鲂鮄科红娘鱼属的鱼